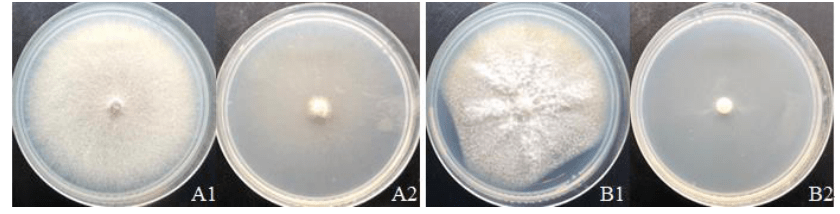
图4:vocs的抗真菌活性:(a)尖孢镰刀菌;(b)番茄镰刀菌(1)对照组;(2)

尖孢镰刀菌

尖孢镰刀菌
图片尺寸455x402
尖孢镰刀菌进行黄瓜回接_发病_接种_试验
图片尺寸534x539
黄瓜枯萎病致病菌—尖孢镰刀菌
图片尺寸480x472
西瓜枯萎病病原菌为尖镰孢菌西瓜专化型,属半知菌亚门真菌.
图片尺寸454x454
冯长海 尖孢镰刀菌
图片尺寸2005x2000
徐和平 尖孢镰刀菌
图片尺寸1080x1920
黄瓜枯萎病致病菌—尖孢镰刀菌
图片尺寸476x480
这是尖孢镰刀菌西瓜专化型(fusarium oxysporum f.sp.
图片尺寸1080x607
徐和平 尖孢镰刀菌
图片尺寸1080x1920
镰刀菌
图片尺寸572x480
尖孢镰刀菌.
图片尺寸754x706
1,病原菌的名称:该病由一种叫做尖孢镰刀菌古巴专化型 (fusarium
图片尺寸1080x478
一种尖孢镰刀菌swh3及其发酵生产黄姜皂素的方法与流程
图片尺寸787x803
真菌大讲堂拾零(十)镰刀菌与枝顶孢
图片尺寸933x792
尖孢镰刀菌平板形态 慕恩生物
图片尺寸640x240
真菌大讲堂拾零(十)镰刀菌与枝顶孢
图片尺寸955x792
一种尖孢镰刀菌及其在植物修复重金属污染土壤中的应用制造技术
图片尺寸1000x753
图4:vocs的抗真菌活性:(a)尖孢镰刀菌;(b)番茄镰刀菌(1)对照组;(2)
图片尺寸840x214
茄病镰刀菌-鹿秀海老师
图片尺寸1440x1080
真菌大讲堂拾零(十)镰刀菌与枝顶孢
图片尺寸1039x2200